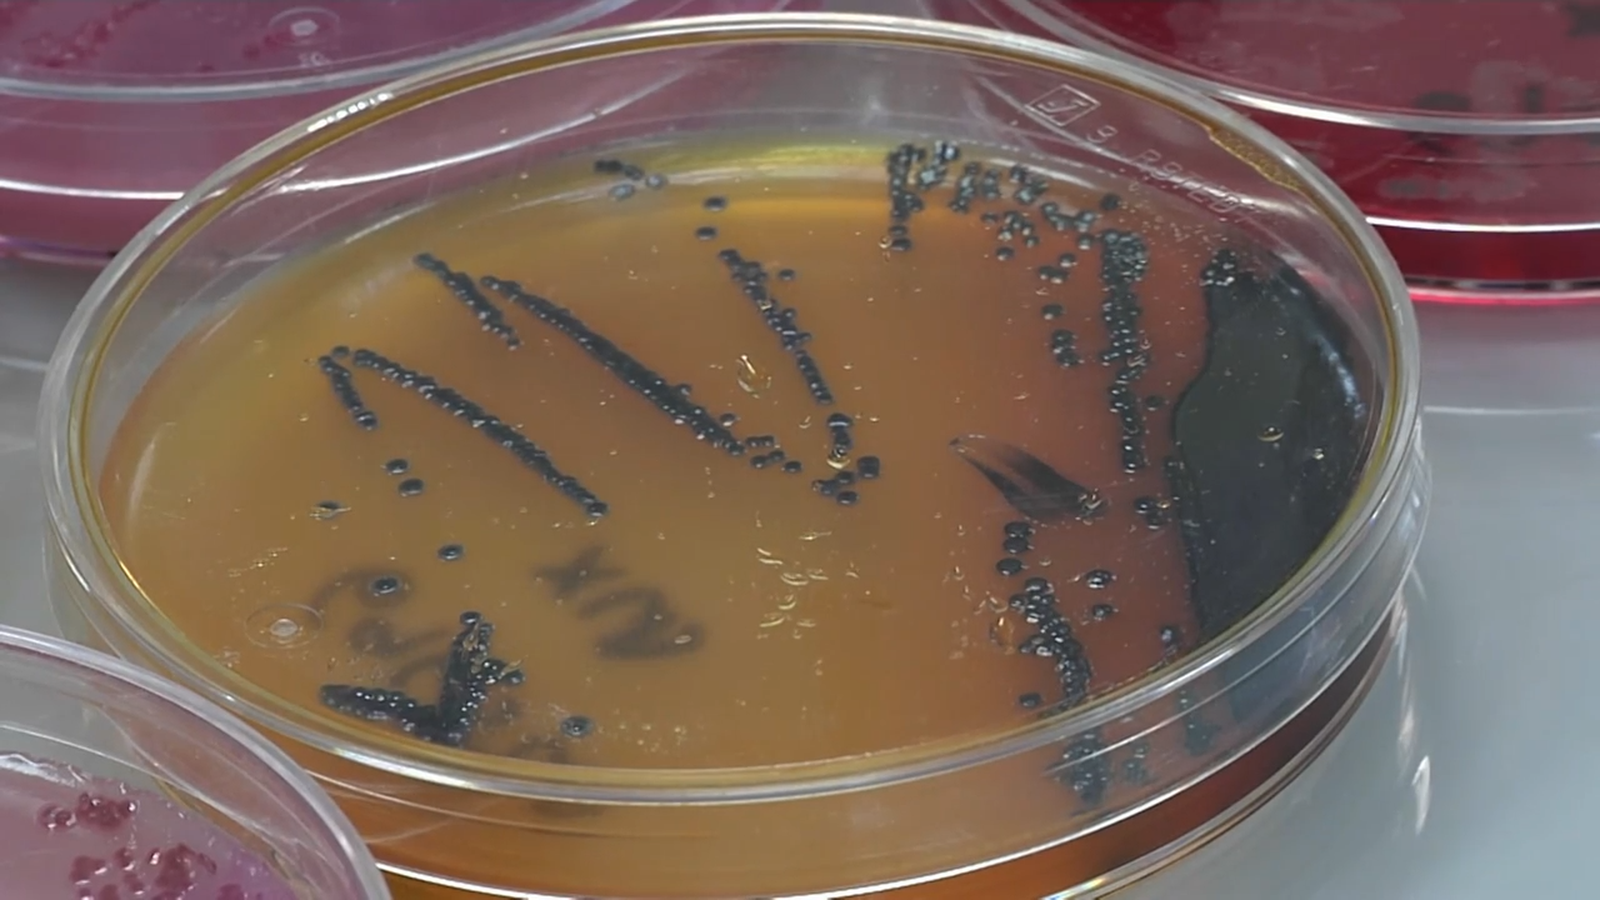
L’estudi de les aigües residuals ha detectat genomes del virus en mostres del 12 de març de 2019.

El coronavirus circulava per Barcelona fa més d’un any, segons un estudi de la UB
L’estudi de les aigües residuals ha detectat genomes del virus en mostres del 12 de març de 2019.
Personal investigador de la Universitat de Barcelona (UB) ha detectat la presència del coronavirus en mostres d’aigües residuals de Barcelona recollides el 12 de març de 2019 en un estudi en col·laboració amb una empresa d’aigües.
S’ha demostrat que hi ha quantitats de genoma del coronavirus en els excrements, que posteriorment arriben a les aigües residuals, pel que l’epidemiologia basada en aquestes aigües és “una eina potencial d’alerta precoç” de la circulació del virus entre la població, assenyalen els investigadors.
Així, es va identificar l’aparició de genomes el 15 de gener de 2020, 41 dies abans de la declaració del primer cas a Espanya. Aquests resultats els van dur a analitzar algunes mostres congelades entre el gener de 2018 i el desembre de 2019, que van resultar negatives a excepció de la del 12 de març de 2019, que va mostrar nivells de SARS-CoV-2 “molt baixos però que va donar clarament positiu amb una prova PCR”.
Això indicaria que la infecció ja estava present abans que es coneguera el primer cas de la Covid-19 al món. Els investigadors han estimat que, atés que la majoria de casos de Covid-19 mostren una simptomatologia similar a la grip, els primers “han quedat emmascarats”.
